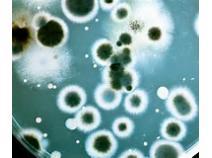

Press release
Bacillus Thuringiensis Market 2017 - Basf Se, Bayer Cropscience, Camson Biotechnologies Limited, Certis Usa
Apex Research, recently published a detailed market research study focused on the "Bacillus Thuringiensis Market" across the global, regional and country level. The report provides 360° analysis of "Bacillus Thuringiensis Market" from view of manufacturers, regions, product types and end industries. The research report analyses and provides the historical data along with current performance of the global Bacillus Thuringiensis industry, and estimates the future trend of Bacillus Thuringiensis market on the basis of this detailed study. The study shares "Bacillus Thuringiensis Market" performance both in terms of volume and revenue.Get Free Sample Copy of Report Here: https://goo.gl/9RJ9jy
Top Manufacturers Analysis of This Report
Basf Se(Germany)
Bayer Cropscience(Germany)
Camson Biotechnologies Limited(India)
Certis Usa(USA)
Isagro Spa(Italy)
Koppert B.V(Netherlands)
Marrone Bio Innovations Inc(USA)
Valent Biosciences Corporation(USA) and W.Neudorff Gmbh(Germany).
The market research report explores the Bacillus Thuringiensis market across the globe along with major regions and countries. The research report provides a detailed study on each and every aspect of "Bacillus Thuringiensis Market". The research report studies the entire value chain from raw material to end user industries. The report also shares import/export statistics along with production and consumption for all major regions and countries. Moreover, the research study classifies the Bacillus Thuringiensis market based on major product types, application and end users industries of Bacillus Thuringiensis. Besides, the report also covers geographical segmentation for Bacillus Thuringiensis market. The report further provides production, capacity, price per region, gross margin, production cost, for all major regions and countries listed in report.
The competitive landscape of the global market for Bacillus Thuringiensis is determined by assessing the major industry participants, production capacity, production capacity utilization rate, Bacillus Thuringiensis market's production chain, pricing by each manufacturer and the revenue generated by each manufacturer in the Bacillus Thuringiensis market globally.
Enquire Before Buying @ https://goo.gl/9YXycv
The worldwide Bacillus Thuringiensis market 2017 is further analyzed on the basis of product pricing, Bacillus Thuringiensis production volume, data pertaining to demand and Bacillus Thuringiensis supply, and the revenue garnered by the product. The report provides upstream and downstream analysis covering major raw material used in manufacturing of Bacillus Thuringiensis along with detailed manufacturing sources. The report also shares list of major raw material manufacturers along with their manufacturing locations. Detailed raw material price trend analysis along with manufacturing cost analysis is also incorporated into the report. Various methodical tools such as investment returns, feasibility, SWOT analysis and market attractiveness analysis has been implemented in the research study to present a comprehensive, detailed study of the industry for Bacillus Thuringiensis across the world.
About Us
“Apex Research” offer latest market research reports and update to serve you with immediate on-line access to professional insights on global industries, companies, products, and trends. Customers can buys different reports across various categories such as Chemica1l and Material, Biotechnology, Healthcare, Food and beverages, Automobile and various sectors. Our Website offers safe and secure online ordering experience, convenient payment options.
Contact Us
Frank Valadez
Business Development Executive
www.apexresearch.biz | sales@apexresearch.biz
Phone: +177390426831
155 North Wacker Drive, Suite 4250
Chicago, IL 60606
This release was published on openPR.
Permanent link to this press release:
Copy
Please set a link in the press area of your homepage to this press release on openPR. openPR disclaims liability for any content contained in this release.
You can edit or delete your press release Bacillus Thuringiensis Market 2017 - Basf Se, Bayer Cropscience, Camson Biotechnologies Limited, Certis Usa here
News-ID: 740476 • Views: …
More Releases from Apex Research
Twist Wrap Packaging Market 2017 - Clondalkin Group Holdings B.V, Catty Corporat …
Apex Research, recently published a detailed market research study focused on the "Twist Wrap Packaging Market" across the global, regional and country level. The report provides 360° analysis of "Twist Wrap Packaging Market" from view of manufacturers, regions, product types and end industries. The research report analyses and provides the historical data along with current performance of the global Twist Wrap Packaging industry, and estimates the future trend of…
Twin Neck Dosing Bottles Market 2017 - Silgan Plastics Corporation, Richmond Con …
Apex Research, recently published a detailed market research study focused on the "Twin Neck Dosing Bottles Market" across the global, regional and country level. The report provides 360° analysis of "Twin Neck Dosing Bottles Market" from view of manufacturers, regions, product types and end industries. The research report analyses and provides the historical data along with current performance of the global Twin Neck Dosing Bottles industry, and estimates the…
Tuning Fork Level Switch Market 2017 - OMEGA, ABB, Aplus Finetek Senso, FineTek, …
Apex Research, recently published a detailed market research study focused on the "Tuning Fork Level Switch Market" across the global, regional and country level. The report provides 360° analysis of "Tuning Fork Level Switch Market" from view of manufacturers, regions, product types and end industries. The research report analyses and provides the historical data along with current performance of the global Tuning Fork Level Switch industry, and estimates the…
Three-Way Catalysts (TWC) Market 2017 - Implats, Kunming Sino-Platinum Metals, H …
Apex Research, recently published a detailed market research study focused on the "Three-Way Catalysts (TWC) Market" across the global, regional and country level. The report provides 360° analysis of "Three-Way Catalysts (TWC) Market" from view of manufacturers, regions, product types and end industries. The research report analyses and provides the historical data along with current performance of the global Three-Way Catalysts (TWC) industry, and estimates the future trend of…
More Releases for Bacillus
Global Bacillus Coagulans Market Competitor Analysis Report 2025
On Mar 2, 2025, Global Info Research released a research report titled "Global Bacillus Coagulans Market 2025 by Manufacturers, Regions, Type and Application, Forecast to 2031". This report provides detailed data analysis of the Bacillus Coagulans market from 2020 to 2031. Including the market size and development trends of Bacillus Coagulans Market, it analyzes market size indicators such as sales, sales volume, average price and CAGR, it also provides a…
Bacillus Thuringiensis Market Size, Share, Growth 2031
Global Bacillus Thuringiensis Market Size was estimated at USD 240.9 million in 2021 and is projected to reach USD 371.9 million by 2028, exhibiting a CAGR of 6.4% during the forecast period.
The Bacillus Thuringiensis Market 2024 Report makes available the current and forthcoming technical and financial details of the industry. It is one of the most comprehensive and important additions to the Prudent Markets archive of market research studies. It…
Bacillus Coagulans Market Analysis by 2020-2025
Global Bacillus CoagulansMarket Overview:
The latest report on the global Bacillus Coagulansmarketsuggests a positive growth rate in the coming years. Analysts have studied the historical data and compared it with the current market scenario to determine the trajectory this market will take in the coming years. The investigative approach taken to understand the various aspects of the market is aimed at giving the readers a holistic view of the global Bacillus…
Bacillus Ciagulans Market: Cosmetics Industry Rapidly Adopting Bacillus Coagulan …
Sales of bacillus coagulans have witnessed sheer proliferation in the recent past in line with rising consumer preference for probiotic diet and growing digestive disorders. The bacillus coagulans market is expected to witness sales surpassing 41 thousand tons by 2019, as per the latest research study by Fact.MR.
Interest in probiotic fortified functional foods and beverages continues to grow across countries. Exhibiting the characteristics of both lactobacillus and bacillus genera, bacillus coagulans has…
Global Bacillus Coagulans Market 2018 - Ganeden, Sabinsa, Mitsubishi
Apex Market Reports, recently published a detailed market research study focused on the “Bacillus Coagulans Market” across the global, regional and country level. The report provides 360° analysis of “Bacillus Coagulans Market” from view of manufacturers, regions, product types and end industries. The research report analyses and provides the historical data along with current performance of the global PP Pipe industry, and estimates the future trend of Bacillus Coagulans on…
Bacillus Thuringiensis Market - Global Industry Analysis 2024
Bacillus Thuringiensis (BT) belongs to the category of bacteria which can be used in numerous chemicals compounds, commonly as pesticides. In microbiological terms, BT is an anaerobic bacterium which inhabits water plants or soil surfaces. It is frequently employed as a suppressor of insects which contribute to the degradation of the quality as well as quantity of plant production. Several other bacteria such as B. spharicus and B. poppilae can…